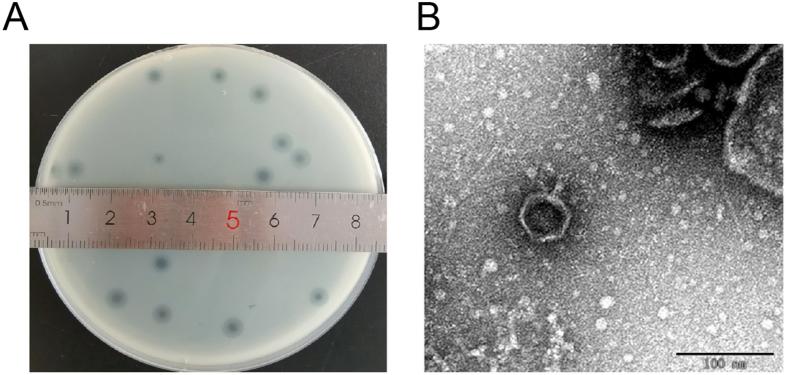
https://cdn.ncbi.nlm.nih.gov/pmc/blobs/2194/10590696/984c875f1980/gr1.jpg

一株裂解 K1 型肺炎克雷伯菌噬菌体 BUCT631 的特性及其对家蚕幼虫的治疗效果。
Characterization of bacteriophage BUCT631 lytic for K1 Klebsiella pneumoniae and its therapeutic efficacy in Galleria mellonella larvae.
机构信息
College of Life Science and Technology, Beijing University of Chemical Technology, Beijing, 100029, China.
Beijing Advanced Innovation Center for Soft Matter Science and Engineering, Beijing University of Chemical Technology, Beijing, 100029, China.
出版信息
Virol Sin. 2023 Oct;38(5):801-812. doi: 10.1016/j.virs.2023.07.002. Epub 2023 Jul 6.
Severe infections caused by multidrug-resistant Klebsiella pneumoniae (K. pneumoniae) highlight the need for new therapeutics with activity against this pathogen. Phage therapy is an alternative treatment approach for multidrug-resistant K. pneumoniae infections. Here, we report a novel bacteriophage (phage) BUCT631 that can specifically lyse capsule-type K1 K. pneumoniae. Physiological characterization revealed that phage BUCT631 could rapidly adsorb to the surface of K. pneumoniae and form an obvious halo ring, and it had relatively favorable thermal stability (4-50 °C) and pH tolerance (pH = 4-12). In addition, the optimal multiplicity of infection (MOI) of phage BUCT631 was 0.01, and the burst size was approximately 303 PFU/cell. Genomic analysis showed that phage BUCT631 has double-stranded DNA (total length of 44,812 bp) with a G + C content of 54.1%, and the genome contains 57 open reading frames (ORFs) and no virulence or antibiotic resistance related genes. Based on phylogenetic analysis, phage BUCT631 could be assigned to a new species in the genus Drulisvirus of the subfamily Slopekvirinae. In addition, phage BUCT631 could quickly inhibit the growth of K. pneumoniae within 2 h in vitro and significantly elevated the survival rate of K. pneumoniae infected Galleria mellonella larvae from 10% to 90% in vivo. These studies suggest that phage BUCT631 has promising potential for development as a safe alternative for control and treatment of multidrug-resistant K. pneumoniae infection.
严重的多药耐药肺炎克雷伯菌(K. pneumoniae)感染突出了对具有这种病原体活性的新型治疗方法的需求。噬菌体治疗是治疗多药耐药肺炎克雷伯菌感染的一种替代治疗方法。在这里,我们报告了一种新型噬菌体(噬菌体)BUCT631,它可以特异性裂解荚膜型 K1 肺炎克雷伯菌。生理特性表明,噬菌体 BUCT631 可以快速吸附在肺炎克雷伯菌的表面并形成明显的晕环,并且它具有相对较好的热稳定性(4-50°C)和 pH 耐受性(pH=4-12)。此外,噬菌体 BUCT631 的最佳感染复数(MOI)为 0.01,爆发量约为 303 PFU/细胞。基因组分析表明,噬菌体 BUCT631 具有双链 DNA(全长 44812 bp),G+C 含量为 54.1%,基因组包含 57 个开放阅读框(ORFs),没有毒力或抗生素耐药相关基因。基于系统发育分析,噬菌体 BUCT631 可以被分配到亚科 Slopekvirinae 属 Drulisvirus 中的一个新种。此外,噬菌体 BUCT631 可以在体外在 2 小时内迅速抑制肺炎克雷伯菌的生长,并使感染的家蚕幼虫的存活率从 10%提高到 90%。这些研究表明,噬菌体 BUCT631 具有作为一种安全替代方法来控制和治疗多药耐药肺炎克雷伯菌感染的巨大潜力。